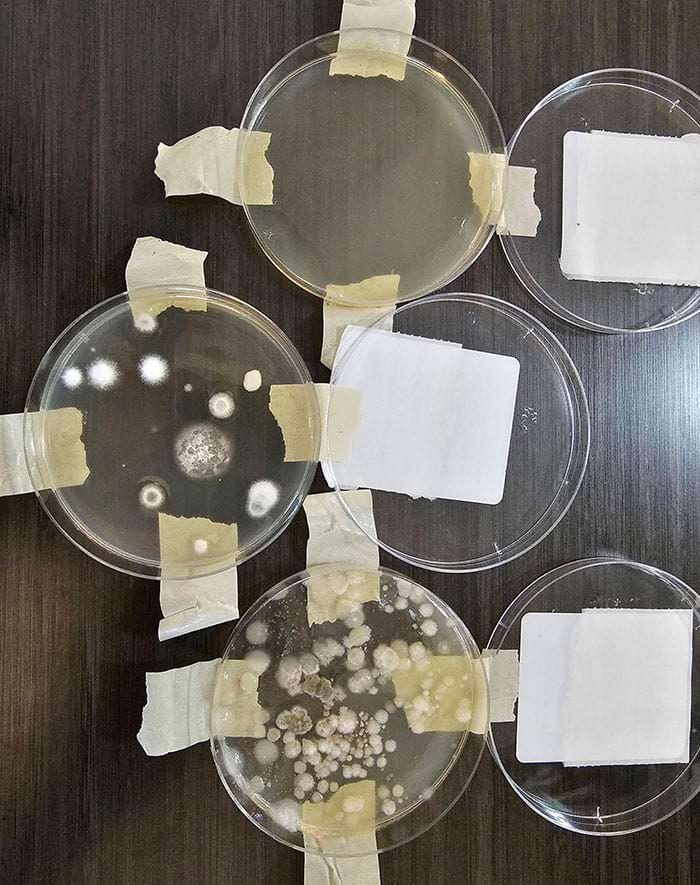

Они забронировали жильё в путешествии, но сильно разочаровались
Появление сервиса Airbnb изменило индустрию гостеприимства во многих положительных аспектах. Онлайн-площадка, где можно забронировать жильё у арендодателей по всему миру, предлагает более аутентичные, удобные и дешевые апартаменты для путешественников, позволяя при этом получать домовладельцам дополнительный доход, сдавая в аренду свое неиспользуемое пространство. Однако, как и в большинстве случаев в жизни, обязательно будут некоторые разочарования или вещи, которые не особо идут по плану. От грибов, растущих на двери ванной, до скрытых камер, прокрутите вниз, чтобы узнать о некоторых из самых странных условий Airbnb, которые пришлось испытать на своей шкуре гостям.
«В моём съемном жилье есть веб-камера, которая просматривает всю гостиную. Я не прав, что отключил её? Мне кажется, это огромное вторжение в личную жизнь!»

Когда фотографии апартаментов не совпадают с реальностью

«Эта скрытая камера, замаскированная под часы в моем Airbnb»

«Ванная в нашем арендованном доме была довольно маленькой»

«Это фото из моего недавнего „роскошного“ жилья, забронированного на Airbnb… Компания действительно позволила мне сменить арендуемое жилье. Но я все равно получил 1 звезду от владельца, который заявил, что я был „неразумным и требовательным гостем“»

«Над ванной в моем Airbnb»

«Я нашел пару наручников, прикрепленных к ножке кровати в моем жилье, снятом в Тихуане»

«В моей съёмной квартире из двери ванной растет гриб»

«Хозяин утверждал, что из его квартиры есть вид на море»

«„Ванная комната“ в моем жилье, снятом на Airbnb, на 100% приведет к встречам с хозяином»

«Дверь в туалет в моем съёмном жилье неэффективна»

Тот случай, когда человек бронирует жильё специально для бильярдного стола

Спальня, в которой предлагается спать гостям этого дома
«Тесты качества воздуха жилья, которой я снял на Airbnb, где хозяин утверждал, что не чувствует запаха плесени. Поддержка отклонила мой возврат денег»

«Забронировал это жильё только из-за ванны»

«Когда вы арендуете жилье через Airbnb на Филиппинах, вы получаете бесплатный белок каждое утро. Клейкая ловушка через 24 часа»

«Это должна была быть уютная квартира, а теперь мне придется остаться здесь на 3 недели, потому что других вариантов нет. Все эти вещи принадлежат владельцу»
«В моём съемном жилье есть веб-камера, которая просматривает всю гостиную. Я не прав, что отключил её? Мне кажется, это огромное вторжение в личную жизнь!»

Когда фотографии апартаментов не совпадают с реальностью

«Эта скрытая камера, замаскированная под часы в моем Airbnb»

«Ванная в нашем арендованном доме была довольно маленькой»

«Это фото из моего недавнего „роскошного“ жилья, забронированного на Airbnb… Компания действительно позволила мне сменить арендуемое жилье. Но я все равно получил 1 звезду от владельца, который заявил, что я был „неразумным и требовательным гостем“»

«Над ванной в моем Airbnb»

«Я нашел пару наручников, прикрепленных к ножке кровати в моем жилье, снятом в Тихуане»

«В моей съёмной квартире из двери ванной растет гриб»

«Хозяин утверждал, что из его квартиры есть вид на море»

«„Ванная комната“ в моем жилье, снятом на Airbnb, на 100% приведет к встречам с хозяином»

«Дверь в туалет в моем съёмном жилье неэффективна»

Тот случай, когда человек бронирует жильё специально для бильярдного стола

Спальня, в которой предлагается спать гостям этого дома

«Тесты качества воздуха жилья, которой я снял на Airbnb, где хозяин утверждал, что не чувствует запаха плесени. Поддержка отклонила мой возврат денег»
«Забронировал это жильё только из-за ванны»

«Когда вы арендуете жилье через Airbnb на Филиппинах, вы получаете бесплатный белок каждое утро. Клейкая ловушка через 24 часа»

«Это должна была быть уютная квартира, а теперь мне придется остаться здесь на 3 недели, потому что других вариантов нет. Все эти вещи принадлежат владельцу»

Только зарегистрированные и авторизованные пользователи могут оставлять комментарии.
0
Все включено))))
- ↓

